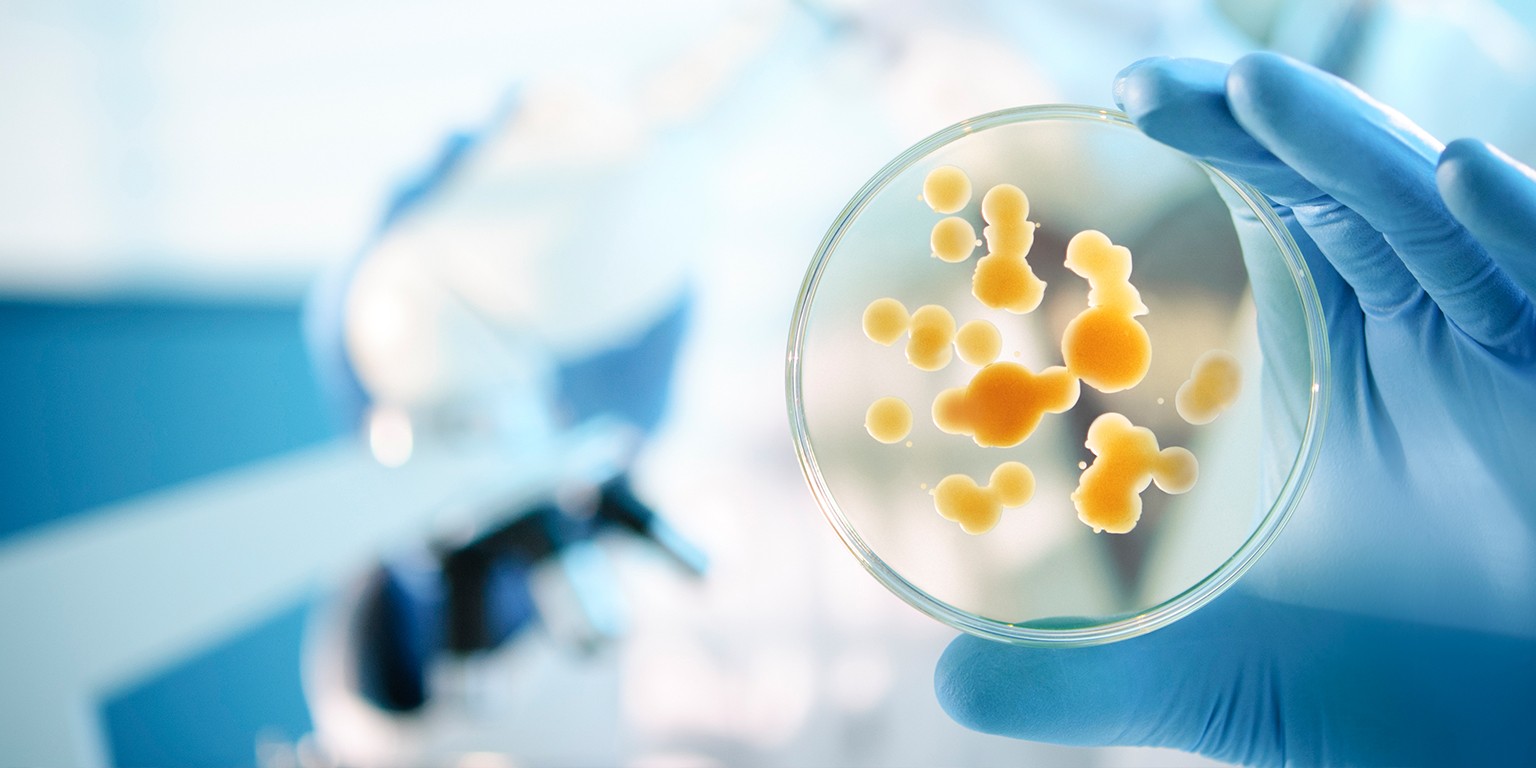
Global Microbial Control Market Trends, and Forecast 2022-2025

We recently discussed a study on the Global Microbial Control Market 2022-2026 research report, which highlights critical inputs related to the global business environment, Microbial Control market share, regional trends, Microbial Control market size, and profit projection. The Microbial Control market report research study also enables users to identify the most significant challenges as well as available growth strategies established by the topmost firms that account for the global competitive environment of the Microbial Control industry.
Download a Free Sample Copy of Microbial Control Market report: https://extrapolate.com/sample/Agritech/Microbial-Control-Market-Insights-2021-Global/8432
Competitive Manufacturers included in Microbial Control Market report are:
* Lonza
* Dow Microbial Control
* Troy Corporation
* ThorGmbh
* Lanxess
* Clariant
The global Microbial Control market report provides a systematic evaluation of the regional and international competitive sectors of the global Microbial Control industry. Major regions of the Microbial Control market include the United States, China, Europe, Japan, India, and Southeast Asia. The regional analysis in the Microbial Control market report provides detailed information about the geological Microbial Control market share as well as the growth rate of each zone over the forecast timeframe.
Furthermore, the global Microbial Control market report includes a fundamental overview of price trends, company, profit margins, and so on. The Microbial Control market report also includes updated statistics and concise knowledge about the global Microbial Control industry. The research document on the Microbial Control market is investigated using both primary and secondary research methods, which serves a dual purpose of estimating industrial findings as well as creating perceptive industrial insights that assist you in gaining a better understanding and clarification of the Microbial Control business environment and competitive resistance.
Microbial Control Market Segmentation by Product Type:
* Product Type I
* Product Type II
* Product Type III
The Application can be Fragmented into:
* Application I
* Application II
* Application III
Regions/countries mentioned in this report are:
• North America
• Europe
• Asia-Pacific
• Latin America
• Middle East & Africa
Browse More Details With TOC: https://extrapolate.com/Agritech/Microbial-Control-Market-Insights-2021-Global/8432


















